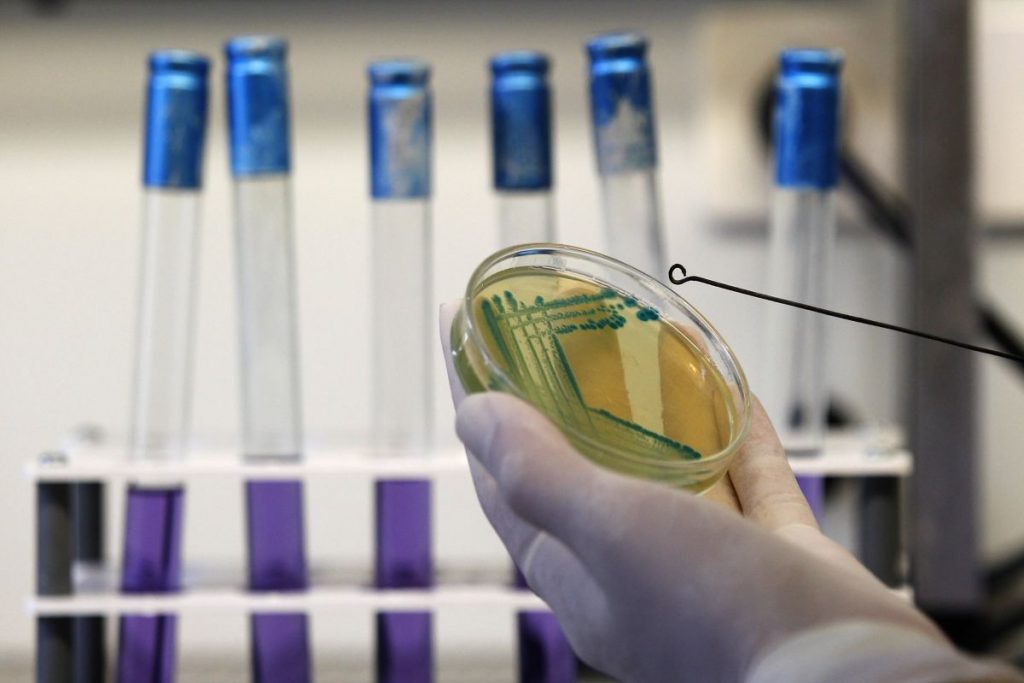
Εντερο: Βακτήρια σε ρόλο εργοστασίου φαρμάκων – Σε ποιο πρόβλημα υγείας μπορούν να δώσουν λύση

Τα μικροπλαστικά – μικροσκοπικά πλαστικά σωματίδια που προκύπτουν κατά κύριο λόγο από την αποδόμηση του πλήθους των πλαστικών προϊόντων που χρησιμοποιούνται ανά τον κόσμο – «κατακλύζουν» τον πλανήτη μας. Βρίσκονται στους ωκεανούς, στα βουνά και στα
σύννεφα, έχουν περάσει στην τροφική αλυσίδα ενώ έχουν εντοπιστεί – και μάλιστα σε ανησυχητικά επίπεδα – και στον ανθρώπινο
Είναι λοιπόν επόμενο το γεγονός ότι πολλοί επιστήμονες ασχολούνται εντατικά με την αποκάλυψη των επιδράσεών τους για τον άνθρωπο και το περιβάλλον.
Αναπάντεχο, ανησυχητικό εύρημα
Τώρα ερευνητές του Πανεπιστημίου της Βοστώνης εντόπισαν μια άγνωστη ως τώρα, αναπάντεχη και άκρως ανησυχητική επίδραση: όπως συγκεκριμένα είδαν τα μικροπλαστικά ενισχύουν την ανθεκτικότητα των βακτηρίων στα αντιβιοτικά!
Κύρια «θύματα» οι προσφυγικοί καταυλισμοί
Συγκεκριμένα οι επιστήμονες ανακάλυψαν, όπως ανέφεραν στο επιστημονικό περιοδικό «Applied and Environmental Microbiology», ότι βακτήρια που εκτέθηκαν σε μικροπλαστικά παρουσίασαν ανθεκτικότητα σε τέσσερις τύπους αντιβιοτικών που χρησιμοποιούνται ευρέως για την αντιμετώπιση λοιμώξεων (αμπικιλλίνη, σιπροφλοξασίνη, δοξυκυκλίνη, στρεπτομυκίνη).
Οι ερευνητές υπογράμμισαν μάλιστα ότι το εύρημα αυτό είναι ιδιαιτέρως ανησυχητικό σε ό,τι αφορά άτομα που ζουν σε υποβαθμισμένες πυκνοκατοικημένες περιοχές, όπως οι προσφυγικοί καταυλισμοί όπου συσσωρεύονται πλαστικά απόβλητα ενώ εξαπλώνονται … σαν αστραπή και οι βακτηριακές λοιμώξεις.
«Το γεγονός ότι υπάρχουν μικροπλαστικά παντού γύρω μας, και ιδίως σε υποβαθμισμένα μέρη όπου η υγιεινή είναι περιορισμένη, αποτελεί το βασικότερο σημείο της μελέτης μας» σημείωσε ο Μοχάμεντ Ζαμάν, καθηγητής Βιοϊατρικής Μηχανικής στο Κολέγιο Μηχανικής του Πανεπιστημίου της Βοστώνης ο οποίος μελετά τη βακτηριακή αντοχή καθώς και την υγεία των προσφύγων και των μεταναστών και προσέθεσε: «Υπάρχει σίγουρα ανησυχία ότι ο κίνδυνος από τα μικροπλαστικά μπορεί να είναι μεγαλύτερος σε κοινότητες που είναι μη προνομιούχες και τα ευρήματά μας καταδεικνύουν την ανάγκη περαιτέρω επιτήρησης και βαθύτερης διερεύνησης των αλληλεπιδράσεων μεταξύ μικροπλαστικών και βακτηρίων».
Σημαντικός παράγοντας το μικροπεριβάλλον των βακτηρίων
Εκτιμάται ότι κάθε χρόνο 4,95 εκατομμύρια θάνατοι παγκοσμίως οφείλονται σε λοιμώξεις ανθεκτικές στα αντιμικροβιακά φάρμακα. Υπάρχουν πλείστες αιτίες για την ανθεκτικότητα των βακτηρίων στα αντιβιοτικά όπως η λανθασμένη χρήση αλλά και η κατάχρηση των αντιβιοτικών θεραπειών.
Ωστόσο ένας πολύ σημαντικός παράγοντας που πυροδοτεί την ανθεκτικότητα είναι το μικροπεριβάλλον – το άμεσο περιβάλλον γύρω από το εκάστοτε βακτήριο – στο οποίο τα μικρόβια πολλαπλασιάζονται.
Το βακτηριακό βιοφίλμ – «ασπίδα»
Στο εργαστήριο του καθηγητή Ζαμάν στο Πανεπιστήμιο της Βοστώνης οι ερευνητές εξέτασαν πώς ένα κοινό βακτήριο, το Escherichia coli (E. coli) αντιδρούσε όταν βρισκόταν «εγκλωβισμένο» σε ένα περιβάλλον με μικροπλαστικά.
«Το πλαστικό παρέχει μια επιφάνεια στην οποία τα βακτήρια προσδένονται και την αποικίζουν» ανέφερε η Νέιλα Γκρος, υποψήφια διδάκτορας στην Επιστήμη Υλικών και τη Μηχανική, πρώτη συγγραφέας της μελέτης και εξήγησε ότι μόλις τα βακτήρια προσδεθούν σε οποιαδήποτε επιφάνεια δημιουργούν ένα βιοφίλμ – μια κολλώδη ουσία που λειτουργεί ως «ασπίδα» προστατεύοντας τα βακτήρια από εισβολείς.
Σαν ένα σπίτι με αδιαπέραστη μόνωση
Παρότι τα βακτήρια μπορούν να δημιουργήσουν βιοφίλμ σε οποιαδήποτε επιφάνεια, η κυρία Γκρος παρατήρησε ότι τα μικροπλαστικά καθιστούσαν τα βακτηριακά βιοφίλμ «αδιαπέραστα» από τα αντιβιοτικά.
«Είδαμε ότι τα βιοφίλμ που αναπτύσσονται σε μικροπλαστικά είναι πολύ πιο ισχυρά και με μεγαλύτερο πάχος σε σύγκριση με εκείνα που αναπτύσσονται σε άλλες επιφάνειες όπως το γυαλί – μοιάζουν με ένα σπίτι το οποίο έχει μόνωση με τους… τόνους» είπε η κυρία Γκρος και συμπλήρωσε ότι έμεινε τόσο έκπληκτη όταν παρατήρησε πόσο μεγάλη ήταν η ανθεκτικότητα του E.coli στα αντιβιοτικά όταν βρισκόταν σε περιβάλλον με μικροπλαστικά σε σύγκριση με άλλα υλικά ώστε αναγκάστηκε να διεξαγάγει τα σχετικά πειράματα πολλές φορές δοκιμάζοντας διαφορετικούς συνδυασμούς αντιβιοτικών και πλαστικών υλικών. Κάθε φορά όμως τα αποτελέσματα ήταν ίδια (εξίσου εντυπωσιακά και ανησυχητικά).
Ανάπτυξη ανθεκτικών οργανισμών εξαιτίας των μικροπλαστικών
«Δείξαμε ότι η παρουσία μικροπλαστικών δεν παρέχει μόνο μια επιφάνεια στα βακτήρια για να προσδεθούν – ουσιαστικώς οδηγεί στην ανάπτυξη ανθεκτικών οργανισμών» τόνισε ο καθηγητής Ζαμάν ο οποίος διευθύνει το Κέντρο Αναγκαστικής Εκτόπισης του Πανεπιστημίου της Βοστώνης το οποίο έχει ως αποστολή τη βελτίωση των συνθηκών διαβίωσης των εκτοπισμένων ανά τον κόσμο.
Προηγούμενες μελέτες είχαν δείξει ότι οι πρόσφυγες, οι αιτούντες άσυλο και γενικώς τα άτομα που εκτοπίζονται αναγκαστικά από τη χώρα τους αντιμετωπίζουν αυξημένο κίνδυνο για ανθεκτικές λοιμώξεις εξαιτίας του ότι ζουν σε καταυλισμούς όπου επικρατούν συνθήκες συνωστισμού ενώ συχνά δεν έχουν επαρκή υγειονομική φροντίδα. «Οι περιβαλλοντικές και κοινωνικές αιτίες των ανθεκτικών στα αντιβιοτικά βακτηρίων δεν μπορούν να αγνοηθούν» είπε ο δρ Ζαμάν.
122 εκ. εκτοπισμένοι παγκοσμίως το 2024
Το 2024 εκτιμάτο ότι υπήρχαν 122 εκατομμύρια εκτοπισμένοι άνθρωποι παγκοσμίως. Κατά τον καθηγητή, η «κυριαρχία» των μικροπλαστικών στον πλανήτη μπορεί να προσθέσει έναν επιπλέον σημαντικό παράγοντα κινδύνου στα ήδη υποχρηματοδοτούμενα και ανεπαρκώς μελετημένα συστήματα υγείας και φροντίδας των μεταναστών.
Μελέτες σε συνθήκες του πραγματικού κόσμου
Το επόμενο βήμα για την ερευνητική ομάδα είναι να εξετάσει αν τα ευρήματα που προέκυψαν στο εργαστήριο είναι τα ίδια και στις συνθήκες του πραγματικού κόσμου.
Οι ερευνητές ευελπιστούν ότι θα ξεκινήσουν μελέτες με συνεργάτες στην Ευρώπη και σε άλλα μέρη του κόσμου προκειμένου να διερευνήσουν αν σε καταυλισμούς προσφύγων εντοπίζονται βακτήρια και ιοί ανθεκτικά στα φάρμακα εξαιτίας των μικροπλαστικών.
Απορρόφηση των αντιβιοτικών πριν φθάσουν στον στόχο τους;
Στοχεύουν επίσης στο να βρουν τους ακριβείς μηχανισμούς που επιτρέπουν στα βακτήρια να «αγκιστρώνονται» τόσο καλά στις πλαστικές επιφάνειες. «Τα πλαστικά είναι άκρως “προσαρμόσιμα” και η μοριακή σύστασή τους μπορεί να βοηθήσει τα βακτήρια να “ανθίσουν”, ωστόσο είναι ασαφές πώς ακριβώς συμβαίνει αυτό» σημείωσε η κυρία Γκρος και συμπλήρωσε ότι μια θεωρία αναφέρει πως τα πλαστικά απωθούν το νερό και άλλα υγρά, γεγονός που επιτρέπει στα βακτήρια να προσδένονται εύκολα επάνω τους.
Ωστόσο με την πάροδο του χρόνου οι πλαστικές επιφάνειες συσσωρεύουν υγρασία και αυτό σημαίνει ότι είναι πιθανό τα μικροπλαστικά να απορροφούν τα αντιβιοτικά προτού εκείνα φθάσουν στα βακτήρια-στόχους τους. Ηταν μάλιστα αξιοσημείωτο ότι, όπως ανακάλυψε η ομάδα από το Πανεπιστήμιο της Βοστώνης, ακόμη και όταν τα μικροπλαστικά έβγαιναν κάποια στιγμή από την εξίσωση, τα βακτήρια που «φιλοξενούσαν» πρωτύτερα διατηρούσαν την ικανότητα να δημιουργούν ισχυρότερα βιοφίλμ.
Ο καταλυτικός ρόλος της βασικής έρευνας
Σύμφωνα με τον δρα Ζαμάν, η ερευνητική ομάδα ελπίζει ότι τα νέα ευρήματα θα ωθήσουν περισσότερους ερευνητές να ασχοληθούν με αυτά τα ζητήματα τα οποία δεν πρέπει να συζητιούνται μόνο υπό το πρίσμα της πολιτικής ή των διεθνών σχέσεων και της μετανάστευσης αλλά οφείλουν να «πατούν γερά» και επάνω στη βασική έρευνα προκειμένου να λυθούν.